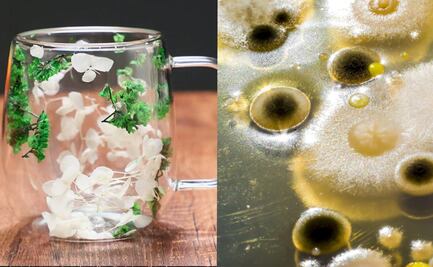
Compra taza de 100 pesos en SHEIN con flores y se convierten en hongos, video viral TikTok

Esta nueva etapa para las plataformas digitales marca un avance importante en la regulación del comercio electrónico en México

Esta nueva etapa para las plataformas digitales marca un avance importante en la regulación del comercio electrónico en México

La empresa es conocida por su política de protección al comprador, que incluye la posibilidad de devolución del dinero

Al acumular puntos, los usuarios pueden canjearlos por descuentos en futuras compras

Dermatitis de contacto por ropa: identifica y evita sus efectos en tu piel

Los comentarios de los internautas variaron desde la incredulidad hasta el interés genuino por realizar compras similares

El año pasado, la Procuraduría Federal del Consumidor advirtió a los mexicanos sobre la calidad de los productos de esta marca
Antes de comprar en línea es recomendable leer los comentarios de los demás compradores

Al comprar productos extranjeros no tienes que realizar pagos extras, porque ya vienen incluidos